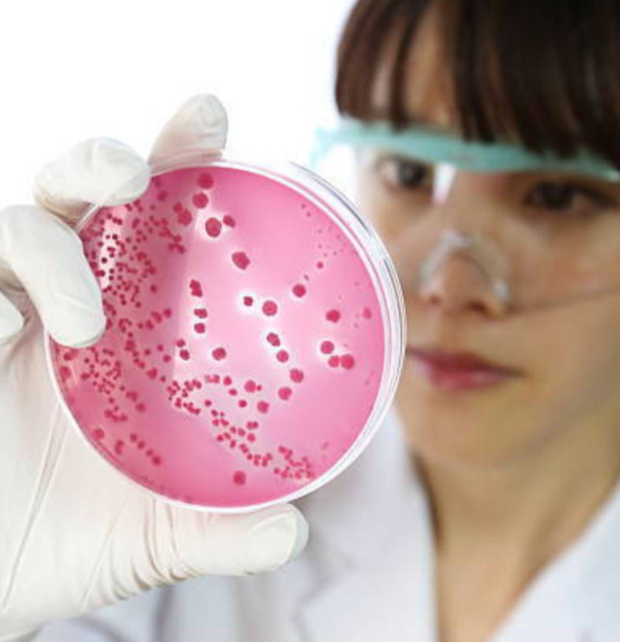

溶連菌感染症に感染するのは3歳から中学生までの子供が多いですが、大人がなることもあります。自然治癒に任せるよりは、薬で早めに完治させた方がこじらせるリスクも少ないです。見分け方や症状を紹介していきます。
溶連菌感染症の症状はどんな感じ?

写真:kakonacl.xsrv.jp
多くの病気は症状が似通っています。特に感染症は素人判断では難しいですよね。溶連菌感染症の症状には、喉の痛み、38~39℃の発熱、発疹といった症状があります。そして、これがもっとも見分けやすいポイントですが、いちご舌になります。いちご舌とは、下に赤いブツブツができて腫れている状態のことです。100%いちご舌になるわけではないのですが、高確率でこの症状が起こります。溶連菌感染症の疑いがあるときは、舌を確認すると良いですね。
合併症が危険!どういったものがある?

写真:tanpopokodomo-clinic.com
溶連菌感染症自体の症状はそれほどひどいものではないのですが、放置するとそこから合併症になる恐れがあります。溶連菌感染症によって人間の体は免疫力が弱まっているので、そこからさまざまな病気になる可能性があるということですね。具体的には、腎炎、リウマチ熱などがあります。これ以外にもいろいろ可能性はありますが、特にこの二つは溶連菌感染症から合併症になる事例として多いです。ちなみに、リウマチ熱の方は特に危険性が高く、心臓に障害が残るリスクもあります。
三種類の抗生物質で対処!溶連菌を死滅させる
写真:woman.mynavi.jp
溶連菌感染症になった際には抗生物質が薬として有効ですが、抗生物質には三種類あります。具体的には、ペニシリン系、セフェム系、マクロライド系の三種類になります。この中から複数処方されるケースもあればどれか一つに絞られるケースもありますが、多くの場合ペニシリン系のみになります。そして、症状が重い場合はセフェム系、ペニシリン系やセフェム系にアレルギーのある方にはマクロライド系、といった使い分けになります。
抗生物質の注意点や副作用を紹介

写真:da-inn.com
まず抗生物質の使用方法ですが、症状が引いてきても最後まで飲み続けることが重要になります。溶連菌は生きた菌なので、一時的に弱ったとしてもそのまま放置すると復活してしまうことがあるのです。そのため、指定された期間しっかり薬を服用し、完全に菌を死滅させるようにしてください。次に副作用についてですが、副作用として下痢や胃のムカムカが起こることがあります。これは想定の範囲内なので大抵の場合問題ありませんが、副作用が重い場合は医師に相談する必要があるでしょう。
完治までの期間の目安はどのくらい?

写真:woman.mynavi.jp
溶連菌感染症は抗生物質を服用した場合、2~3週間で完治するケースが多いです。ただし、症状が治まるのは3日程度です。発熱や発疹が3日程度でなくなることが多いのですが、先ほど説明した通りここで薬の服用を辞めるのはNGです。菌は体内にまだ残っており、復活する可能性があります。菌が復活する前に、徹底的に死滅させることが重要になります。
まとめ
溶連菌感染症の薬や用法、副作用について紹介してきました。溶連菌感染症は放置すると合併症の恐れがあるので早めに抗生物質で対処すること、薬は自己判断で途中で辞めないこと、などが重要になります。溶連菌は生きた菌なので、薬に対抗して進化してくることもあります。中途半端に薬を服用するとかえって溶連菌を強化してしまう可能性もあるので、服用する際はきちんと継続し、徹底的に溶連菌を死滅させてください。



